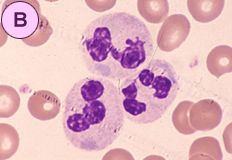

Q16. 好中球の形態所見について正しいものはどれですか。(2010.2 発信)
PB-MG.X1000
![]() |
![]() |
|
|---|---|---|
![]() |
||
| 形態所見について | |
| 1 | 正常である。 |
|---|---|
| 2 | 細胞質に顆粒異常がみられる。 |
| 3 | 細胞質にデーレ小体がみられる。 |
| 4 | 核に形状異常がみられる。 |
| 考えられる疾患について | |
| 1 | 正常 |
|---|---|
| 2 | メイ・ヘグリン(May-Hegglin)異常症 |
| 3 | ペルゲル・ヒュエット(Pelger-Huet)異常症 |
| 4 | エルダー・レイリー(Alder-Reilly)異常症 |
| 5 | 類白血病反応 |